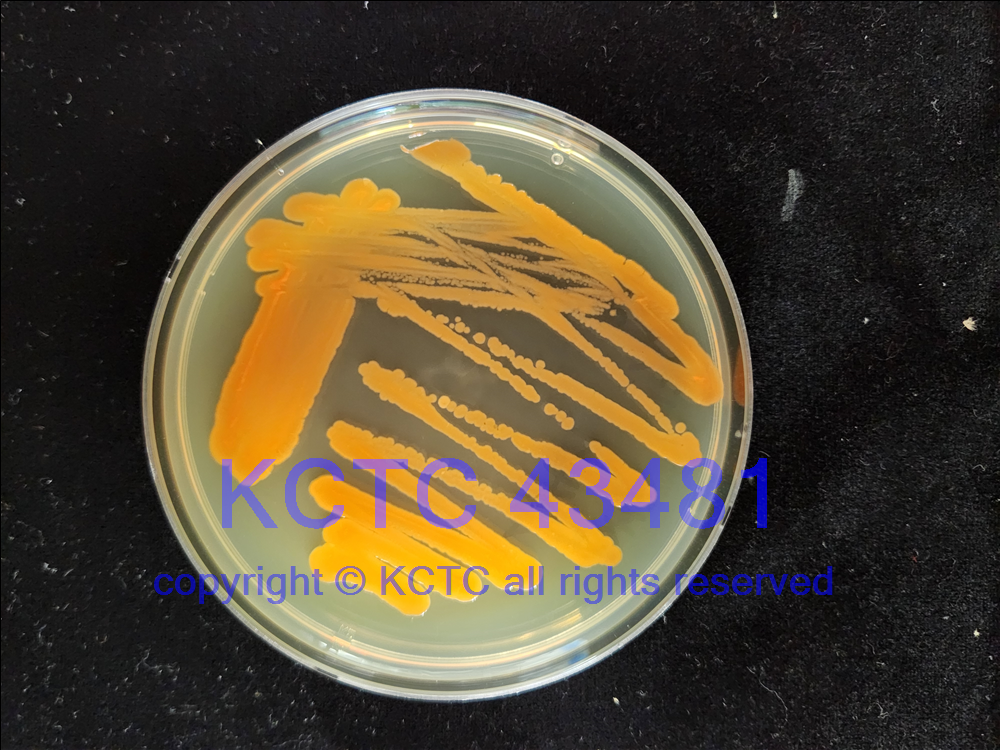

KCTC No. 43481
(KCTC Other No.)
Resource Type Bacteria
Name Bacillus infantis
Type Strain No
Biosafty Level 1
LMO No
Synonym
Phylum (ex Phylum) Bacillota (Firmicutes)
Genome Information
History <- Na-Ri Shin, Korean Collection for Type Cultures (KCTC), KRIBB
Source From Korean traditional salted seafood Jeotgal (Oncorhynchus masou), Traditional market named Samgoeul Market in Jeongeup, Jeollabuk-do, KOREA, REPUBLIC OF
Other Collection No. 0.2B2O-1
Reference
KCTC Media No. KCTC media No. 3 Brain Heart Infusion Agar
Oxygen Requirement Aerobic
Temperature 25 ℃
pH 7-8
Incubation Time 2 d [???? ???? ????? ??, ?? ? ????? ??? ?? ?? ? ??]